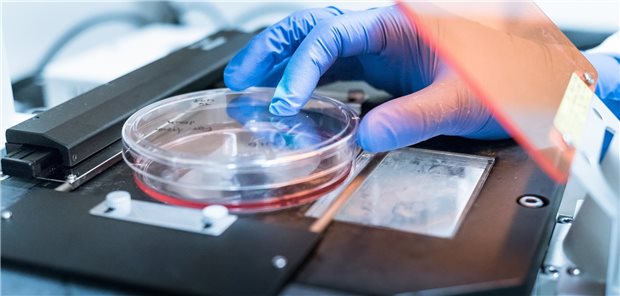

Vorwurf der Fehldiagnostik
Verurteilter Pathologe im Saarland erneut vor Gericht
Saarbrücken. Wegen Totschlags muss sich ein bereits verurteilter früherer Pathologe aus St. Ingbert bald erneut vor dem Landgericht Saarbrücken verantworten. In dem neuen Verfahren geht es darum, dass der Angeklagte in zwei Fällen Fehldiagnosen bei der Begutachtung von Gewebeproben-Präparaten gestellt haben soll, erklärte das Landgericht Saarbrücken. In einem Fall soll ein Patient gestorben sein.
Nach dem Prozessauftakt am 6. Februar hat das Gericht bis zum 15. März acht weitere Verhandlungstage angesetzt. Der Angeklagte, der zunächst für einige Tage auf freien Fuß gekommen war, befindet sich wegen der beiden neuen Fälle wieder in Haft.
Bereits im Juli war der damals 63-Jährige wegen fahrlässiger Tötung, schwerer Körperverletzung sowie in drei Fällen wegen fahrlässiger Körperverletzung verurteilt worden. Unter anderem soll es durch falsche Diagnosen zu nicht notwendigen Behandlungen und Eingriffen wie etwa Chemotherapien, Brust-, Darm- und Gesichtsoperationen gekommen sein. Das Urteil ist noch nicht rechtskräftig. (dpa)